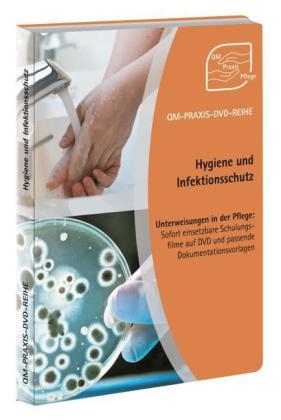
QM-PRAXIS-DVD-Reihe Unterweisungen in der Pflege: Hygiene und Infektionsschutz

Die besten Übungen. Die richtige Ernährung
Online Resource
2018
|
Humboldt
ISBN: 9783842688612
CHF 26,55 (inkl. MwSt)
- Versand in
10-15 Tagen